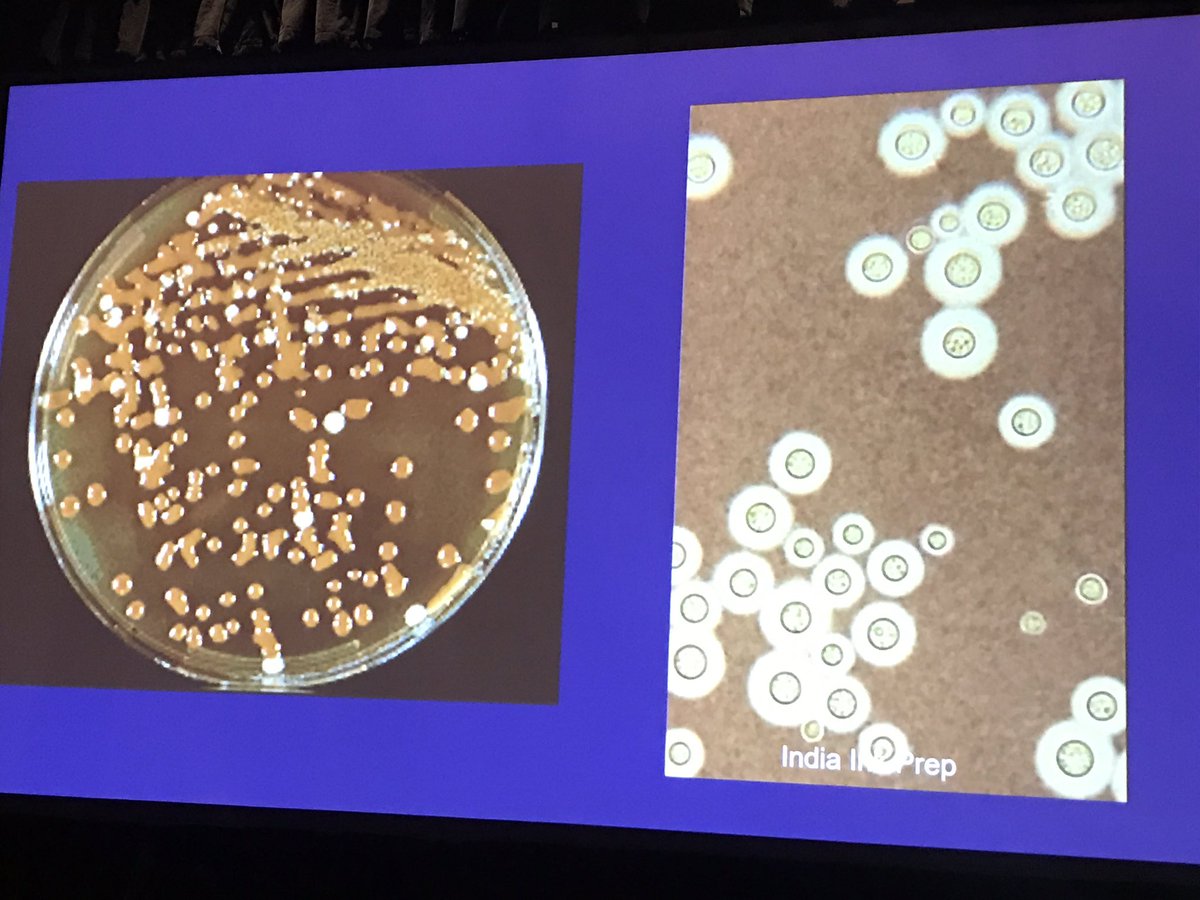
Cutaneous cryptococcal infection | grown on bird seed agar #Dermpath #dermatology #microbiology #boardfodder #PracticalSymposium17

Annie O. Morrison MD
@anniemorrisonmd
#Path/#dermpath 🔬 #MorrisonTechnique for iPhone photomics | faves: #melanasty #fungusamongus & NET's | T/RT ≠ medical advice | coffee addict
ID: 3015188975
03-02-2015 19:57:38
1,1K Tweet
1,1K Followers
428 Following





Cutaneous myiasis "Maggots will grow in your skin!" -Clay Cockerell #PracticalSymposium17 #dermatology #dermpath #infectiousdisease






ALK mutations in Spitz nevi have characteristic spindle cells Clay Cockerell's lecture at #PracticalSymposium17 #dermpath #dermatology


Annie O. Morrison MD Clay Cockerell @PrDermSymposium Maybe not always. e.g. x.com/Dermpathl/stat… #dermpath


Annie O. Morrison MD Here's a case Nathan Harvey had of empd with BCC on the scalp ncbi.nlm.nih.gov/pubmed/?term=W… #dermpath #pathology #dermatology


Amazing medical-legal talk for #Dermatology and #Dermpath by Whitney A High MD,JD at #PracticalSymposium17 👌🏼👍🏼🔬#pathology #medlaw


Last day of Dr Clay Cockerell's Cockerell Dermatopathology excellent course. Learned many things. Looking forward to next year!



Thank you Jerad Gardner, MD @phmckee1948 & Kabeer Shah, DO for your help w/ this #SoMe presentation #PracticalSymposium17 @PrDermSymposium #Dermpath x.com/cockerelldp/st…

Honoring my dad, Dr Dennis Simpson, w/ the Distinguished Directorship in Cardiology Pullman Regional Hospital @PalouseMedical WSU Pullman #livinglegacy Doubleback